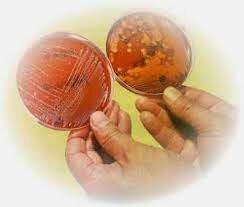
Robert Koch (Cultivos puros)

-
 A partir del descubrimiento del microscopio, Hooke observó un corte de tejido de corcho y descubrió una cavidades muy pequeñas a las que llamó células. Si bien eran células muertas, fue el primero en describirlas. Él marcó el comienzo de la teoría celular, que postula que "todos los seres vivos están compuestos por células".
A partir del descubrimiento del microscopio, Hooke observó un corte de tejido de corcho y descubrió una cavidades muy pequeñas a las que llamó células. Si bien eran células muertas, fue el primero en describirlas. Él marcó el comienzo de la teoría celular, que postula que "todos los seres vivos están compuestos por células". -
 Era un vendedor de telas y no tenía estudios, pero consiguió convertirse en uno de los científicos más trascendentes de la historia de la biología. Observó por primera vez los microorganismos a través de lentes de aumento. Realizó dibujos detallados de los "animálculos" en agua de lluvia, en sus propias heces, y en material raspado de sus dientes. Esos dibujitos ya se han identificado como representaciones de bacterias y protozoos.
Era un vendedor de telas y no tenía estudios, pero consiguió convertirse en uno de los científicos más trascendentes de la historia de la biología. Observó por primera vez los microorganismos a través de lentes de aumento. Realizó dibujos detallados de los "animálculos" en agua de lluvia, en sus propias heces, y en material raspado de sus dientes. Esos dibujitos ya se han identificado como representaciones de bacterias y protozoos. -
En esta etapa, de lenta acumulación de observaciones (desde 1675 aproximadamente hasta la mitad del siglo XIX), que arranca con el descubrimiento de los microorganismos por Leeuwenhoek (1675).
-
 El sistema de nomenclatura de los organismos que se usa en la actualidad, fue establecida por Carolus Linnaeus. La nomenclatura científica asigna dos nombres a cada organismo: el del género es el primer nombre y siempre se escribe con mayúscula, a continuación va el epíteto específico (nombre de la especie) que se escribe con minúscula. Ambos se subrayan o se escriben en bastardilla.
El sistema de nomenclatura de los organismos que se usa en la actualidad, fue establecida por Carolus Linnaeus. La nomenclatura científica asigna dos nombres a cada organismo: el del género es el primer nombre y siempre se escribe con mayúscula, a continuación va el epíteto específico (nombre de la especie) que se escribe con minúscula. Ambos se subrayan o se escriben en bastardilla. -
 El caso de la Generación Espontánea de los microrganismos apareció fortalecerse cuando Needham descubrió que aún después de haber calentado líquidos nutritivos, antes de verterlos en frascos cubiertos las soluciones enfriadas eran rápidamente invadidas por microorganismos. Concluyó que los microbios se desarrollaban espontáneamente de los líquidos.
El caso de la Generación Espontánea de los microrganismos apareció fortalecerse cuando Needham descubrió que aún después de haber calentado líquidos nutritivos, antes de verterlos en frascos cubiertos las soluciones enfriadas eran rápidamente invadidas por microorganismos. Concluyó que los microbios se desarrollaban espontáneamente de los líquidos. -
 Años después Spallanzani, sugirió la posibilidad de que los microorganismos del aire hubieran ingresado en las soluciones de Needham después de que fueran hervidas. Demostró que en los líquidos nutritivos calentados después de haber sellado el frasco no se producían crecimiento microbiano.
Años después Spallanzani, sugirió la posibilidad de que los microorganismos del aire hubieran ingresado en las soluciones de Needham después de que fueran hervidas. Demostró que en los líquidos nutritivos calentados después de haber sellado el frasco no se producían crecimiento microbiano. -
 Médico y científico inglés que fue el pionero de la vacuna contra la viruela. A menudo se lo llama "el padre de la inmunología", porque su trabajo ha salvado muchas vidas.
Médico y científico inglés que fue el pionero de la vacuna contra la viruela. A menudo se lo llama "el padre de la inmunología", porque su trabajo ha salvado muchas vidas. -
 Un gran descubrimiento en la bacteriología moderna. La primera prueba experimental de un agente biológico como causa de una enfermedad epidémica la proporcionó Agostino Bassi en 1835, demostrando que cierta enfermedad del gusano de seda, que había hecho en Lombardía, se debía al hongo Botrytis bassiana.
Un gran descubrimiento en la bacteriología moderna. La primera prueba experimental de un agente biológico como causa de una enfermedad epidémica la proporcionó Agostino Bassi en 1835, demostrando que cierta enfermedad del gusano de seda, que había hecho en Lombardía, se debía al hongo Botrytis bassiana. -
 Había demostrado a sus colegas, que en esa época no desinfectaban sus manos, habitualmente transmitían infecciones (fiebre puerperal) de una paciente obstétrica a otra. En un mundo en donde no entendían los gérmenes, intento aplicar la ciencia para detener las infecciones, implementando un sistema de lavado de manos en Viena tratando de convencer a colegas que la fiebre puerperal era causada por contactos con cuerpos muertos y solo debían "lavarse las manos" con solución antisépticas.
Había demostrado a sus colegas, que en esa época no desinfectaban sus manos, habitualmente transmitían infecciones (fiebre puerperal) de una paciente obstétrica a otra. En un mundo en donde no entendían los gérmenes, intento aplicar la ciencia para detener las infecciones, implementando un sistema de lavado de manos en Viena tratando de convencer a colegas que la fiebre puerperal era causada por contactos con cuerpos muertos y solo debían "lavarse las manos" con solución antisépticas. -
 DeBary fue botánico, microbiólogo, micólogo alemán, considerado fundador del estudios de las enfermedades vegetales. Denominó a las enfermedades producidas por hongos y bacterias dentro o sobre las plantas como enfermedades micóticas.
DeBary fue botánico, microbiólogo, micólogo alemán, considerado fundador del estudios de las enfermedades vegetales. Denominó a las enfermedades producidas por hongos y bacterias dentro o sobre las plantas como enfermedades micóticas. -
 Pasteur descubrió que los microorganismos denominados levaduras, convertían los azúcares en alcohol en ausencia del aire. Este proceso se denomino fermentación.
Pasteur descubrió que los microorganismos denominados levaduras, convertían los azúcares en alcohol en ausencia del aire. Este proceso se denomino fermentación. -
A partir de las investigaciones de Pasteur, hubo una explosión de descubrimientos en microbiología, que duró cerca de 60 años. Este período se denominó la Edad de Oro de la Microbiología. Se realizaron avances rápidos encabezados por Pasteur y Koch que condujeron al establecimiento de la Microbiología como ciencia.
-
De cultivo de microorganismos, que llega hasta finales del siglo XIX, donde las figuras de Pasteur y Koch encabezan el logro de cristalizar a la Microbiología como ciencia experimental bien asentada.
-
 Virchow desafió la generación espontánea con el concepto de biogénesis, afirmando que las células vivas sólo podían surgir de células vivas preexistentes.
Virchow desafió la generación espontánea con el concepto de biogénesis, afirmando que las células vivas sólo podían surgir de células vivas preexistentes. -
 Una serie de experimentos ingeniosos y persuasivos, Pasteur demostró que los microorganismos están presentes en el aire y pueden contaminar soluciones estériles pero que el aire no crea lo microbios.
Una serie de experimentos ingeniosos y persuasivos, Pasteur demostró que los microorganismos están presentes en el aire y pueden contaminar soluciones estériles pero que el aire no crea lo microbios. -
 El proceso de pasteurización fue llamado así liego que Lois Pasteur, descubriera que organismos contaminantes productores de la enfermedad de los vinos podían ser eliminados aplicando temperatura. Luego se empleó a otros productos para lograr su conservación.
El proceso de pasteurización fue llamado así liego que Lois Pasteur, descubriera que organismos contaminantes productores de la enfermedad de los vinos podían ser eliminados aplicando temperatura. Luego se empleó a otros productos para lograr su conservación. -
 Descubrió que el fenol (ácido carbólico) destruía las bacterias de modo que comenzó a tratar las heridas quirúrgicas con una solución de fenol. Esta práctica redujo tanto la incidencia de infecciones y muertes que otros cirujanos la adoptaron de inmediato. La técnica de Lister fue uno de los primeros intentos médicos de controlar las infecciones causadas por microorganismos. Sus hallazgos demostraron que los microrganismos causan infecciones de las heridas quirúrgicas.
Descubrió que el fenol (ácido carbólico) destruía las bacterias de modo que comenzó a tratar las heridas quirúrgicas con una solución de fenol. Esta práctica redujo tanto la incidencia de infecciones y muertes que otros cirujanos la adoptaron de inmediato. La técnica de Lister fue uno de los primeros intentos médicos de controlar las infecciones causadas por microorganismos. Sus hallazgos demostraron que los microrganismos causan infecciones de las heridas quirúrgicas. -
 Físico alemán, interesado en la causa del carbunco, una enfermedad que estaba destruyendo al ganado bovino y ovino en Europa. Koch descubrió las bacterias con forma de bastón (Bacillus anthracis) en la sangre de los animales muertos por carbunco. Estableció los postulados de Koch para identificar microbios específicos causantes de enfermedades.
Físico alemán, interesado en la causa del carbunco, una enfermedad que estaba destruyendo al ganado bovino y ovino en Europa. Koch descubrió las bacterias con forma de bastón (Bacillus anthracis) en la sangre de los animales muertos por carbunco. Estableció los postulados de Koch para identificar microbios específicos causantes de enfermedades. -
 Pasteur descubrió el modo en que actúan las vacunas. Se dio cuenta que la bacteria que produce el cólera aviario perdía su capacidad de causar enfermedad (pérdida de su virulencia o conversión en avirulenta) después de ser cultivada en el laboratorio durante períodos prolongados. Sin embargo, este microorganismo podía inducir inmunidad contra infecciones ulteriores por cepas virulentas. El descubrimiento de este fenómeno condujo al experimento exitoso de Jenner con el virus de la viruela vacuna.
Pasteur descubrió el modo en que actúan las vacunas. Se dio cuenta que la bacteria que produce el cólera aviario perdía su capacidad de causar enfermedad (pérdida de su virulencia o conversión en avirulenta) después de ser cultivada en el laboratorio durante períodos prolongados. Sin embargo, este microorganismo podía inducir inmunidad contra infecciones ulteriores por cepas virulentas. El descubrimiento de este fenómeno condujo al experimento exitoso de Jenner con el virus de la viruela vacuna. -
Fue nombrado miembro del Departamento de Salud Imperial de Berlín, realizando su descubrimiento más importante, el del bacilo de la tuberculosis (Bacilo de Koch). El trabajo de Koch consistió en aislar el microorganismo causante de una enfermedad y hacerlo crecer en un cultivo puro.
Fue nombrado miembro del Departamento de Salud Imperial de Berlín, realizando su descubrimiento más importante, el del bacilo de la tuberculosis (Bacilo de Koch). El trabajo de Koch consistió en aislar el microorganismo causante de una enfermedad y hacerlo crecer en un cultivo puro. -
 Médico e investigador clínico cubano. Descubrió la importancia de un vector biológico, el mosquito Aedes aegypti (conocido Steegomyia fasciata) en la transmisión de la fiebre amarilla.
Médico e investigador clínico cubano. Descubrió la importancia de un vector biológico, el mosquito Aedes aegypti (conocido Steegomyia fasciata) en la transmisión de la fiebre amarilla. -
 Koch anunció su descubrimiento sobre el agente que provoca la tuberculosis, a la cual se la llamó por un tiempo bacilo de Koch. Actualmente se la conoce como Mycobacterium tuberculosis.
Koch anunció su descubrimiento sobre el agente que provoca la tuberculosis, a la cual se la llamó por un tiempo bacilo de Koch. Actualmente se la conoce como Mycobacterium tuberculosis.
La tuberculosis era una enfermedad común y mortal en los años 1800. -
 En 1883 Koch trabajó en un equipo de investigación francés en Alejandría, Egipto estudiando el cólera. También trabajó en la India donde aisló e identificó la bacteria vidrio que causaba el cólera aunque nunca consiguió probarlo con sus experimentos.
En 1883 Koch trabajó en un equipo de investigación francés en Alejandría, Egipto estudiando el cólera. También trabajó en la India donde aisló e identificó la bacteria vidrio que causaba el cólera aunque nunca consiguió probarlo con sus experimentos. -
 Melchnikoff fue quien descubrió y describió el fenómeno de la fagocitosis y en función de ellos ha sido considerado como el "el padre de la inmunidad celular".
Melchnikoff fue quien descubrió y describió el fenómeno de la fagocitosis y en función de ellos ha sido considerado como el "el padre de la inmunidad celular". -
 La bacteria Escherichia coli fue inicialmente aislada y descripta por el pediatra alemán Escherich, quien demostró su existencia como húsped habitual del intestino. La denominó Bacterium coli commune, que puede traducirse como "bacteria común del colon".
La bacteria Escherichia coli fue inicialmente aislada y descripta por el pediatra alemán Escherich, quien demostró su existencia como húsped habitual del intestino. La denominó Bacterium coli commune, que puede traducirse como "bacteria común del colon". -
 Después de ensayos coronados exitosamente contra enfermedades de animales, como el cólera de las gallinas. En 1885 aplica su tratamiento al joven Joseph Meister, quien había estado expuesto al virus de la rabia y logra salvarle la vida. Luego, muchas personas fueron tratadas con los mismos procedimientos.
Después de ensayos coronados exitosamente contra enfermedades de animales, como el cólera de las gallinas. En 1885 aplica su tratamiento al joven Joseph Meister, quien había estado expuesto al virus de la rabia y logra salvarle la vida. Luego, muchas personas fueron tratadas con los mismos procedimientos. -
 Fue un microbiólogo alemán a quien se le atribuye la invención de la placa de Petri, mientras trabajaba como asistente de Robert Koch. Gracias a la placa de Petri se consiguió aislar los microorganismos que provocaban enfermedades como la cólera o la difteria, encontrando posteriormente.
Fue un microbiólogo alemán a quien se le atribuye la invención de la placa de Petri, mientras trabajaba como asistente de Robert Koch. Gracias a la placa de Petri se consiguió aislar los microorganismos que provocaban enfermedades como la cólera o la difteria, encontrando posteriormente. -
 Médico y bacteriólogo japonés, logró el primer cultivo de Clostridium tetani. Posteriormente la toxina del tétanos fue descubierta por Knuf Faber en 1899, condición previa para el éxito del desarrollo de la vacuna.
Médico y bacteriólogo japonés, logró el primer cultivo de Clostridium tetani. Posteriormente la toxina del tétanos fue descubierta por Knuf Faber en 1899, condición previa para el éxito del desarrollo de la vacuna. -
 Su principal contribución a la medicina fue la teoría de la Inmunidad de cadena lateral, que establecía la base química para la especificidad de la respuesta inmunológica.
Su principal contribución a la medicina fue la teoría de la Inmunidad de cadena lateral, que establecía la base química para la especificidad de la respuesta inmunológica. -
 Kitasato y Behring, vacunaron conejillos a base de una toxina de difteria con tratamiento térmico. Demostraron que los productos sanguíneos de los conejillos contenían una sustancia que prevenía los efectos nocivos de C. diphtheriae y su toxina cuando los conejillos eran expuestos nuevamente a dosis letales de la bacteria y la toxina. De esa manera se podía curar la difteria en un animal se le inyectaba sérico de uno vacunado. La sustancia era antitoxina el tratamiento terapia sérica.
Kitasato y Behring, vacunaron conejillos a base de una toxina de difteria con tratamiento térmico. Demostraron que los productos sanguíneos de los conejillos contenían una sustancia que prevenía los efectos nocivos de C. diphtheriae y su toxina cuando los conejillos eran expuestos nuevamente a dosis letales de la bacteria y la toxina. De esa manera se podía curar la difteria en un animal se le inyectaba sérico de uno vacunado. La sustancia era antitoxina el tratamiento terapia sérica. -
 Informó que los microorganismos causantes de la enfermedad del mosaico del tabaco era tan diminutos que atravesaba filtros lo bastante fino como la impedir el paso de todas las bacterias conocidas. En esa época Iwanowski el término de virus que se da ahora.
Informó que los microorganismos causantes de la enfermedad del mosaico del tabaco era tan diminutos que atravesaba filtros lo bastante fino como la impedir el paso de todas las bacterias conocidas. En esa época Iwanowski el término de virus que se da ahora. -
 Fue el pensador imaginativo que inició la revolución de la quimioterapia. De estudiante especulaba sobre una "bala mágica", que pudiera alcanzar al patógeno sin dañar al huésped. Una bala similar fue un agente quimioterápico denominado salvarsán, que ofrecía la salvación de la sífilis y contenía arsénico.
Fue el pensador imaginativo que inició la revolución de la quimioterapia. De estudiante especulaba sobre una "bala mágica", que pudiera alcanzar al patógeno sin dañar al huésped. Una bala similar fue un agente quimioterápico denominado salvarsán, que ofrecía la salvación de la sífilis y contenía arsénico. -
 El reconocimiento de la enfermedad de Chagas o Trypanosomiosis americana se inicia con el descubrimiento del agente causal, Trypanosoma cruzi, por el brillante médico brasilero Carlos Chagas. Encontró el parásito vector, en el ser humano, y describió las lesiones patológicas tanto animales inoculados experimentalmente con T. cruzi, como en las autopsias de los casos humanos . Estos hallazgos son contribuciones científicas pioneras sobre esta enfermedad en el mundo.
El reconocimiento de la enfermedad de Chagas o Trypanosomiosis americana se inicia con el descubrimiento del agente causal, Trypanosoma cruzi, por el brillante médico brasilero Carlos Chagas. Encontró el parásito vector, en el ser humano, y describió las lesiones patológicas tanto animales inoculados experimentalmente con T. cruzi, como en las autopsias de los casos humanos . Estos hallazgos son contribuciones científicas pioneras sobre esta enfermedad en el mundo. -
 De su descubrimiento destaca el del virus que lleva su nombre, un tipo de sarcoma. En 1911 Rous consiguió aislar tal virus de un tumor canceroso de un pollo; infecto con el a otros pollos que desarrollaron el mismo tumor. (ahora conocido como el Virus de Sarcoma de Rous, un retrovirus).
De su descubrimiento destaca el del virus que lleva su nombre, un tipo de sarcoma. En 1911 Rous consiguió aislar tal virus de un tumor canceroso de un pollo; infecto con el a otros pollos que desarrollaron el mismo tumor. (ahora conocido como el Virus de Sarcoma de Rous, un retrovirus). -
 Médico y bacteriólogo escocés. A punto de tirar unas palcas de cultivo contaminado por un hongo filamentoso, echó un segundo vistazo a la forma de crecimiento que aparecía en las placas contaminadas; alrededor del hongo había una zona clara en la que el crecimiento bacteriano estaba inhibido. Fleming había encontrado un hongo capaz de inhibir el crecimiento de una bacteria. Este hongo fue identificado como Penicillium chrysogenum que Fleming denominó penicilina.
Médico y bacteriólogo escocés. A punto de tirar unas palcas de cultivo contaminado por un hongo filamentoso, echó un segundo vistazo a la forma de crecimiento que aparecía en las placas contaminadas; alrededor del hongo había una zona clara en la que el crecimiento bacteriano estaba inhibido. Fleming había encontrado un hongo capaz de inhibir el crecimiento de una bacteria. Este hongo fue identificado como Penicillium chrysogenum que Fleming denominó penicilina. -
 Un adelanto fundamental en la inmunología sucedió con Lancefield cuando propuso la clasificación de los estreptococos según serotipos (variantes dentro de una especie) sobre la base de ciertos componentes de la pared celular de las bacterias. Estos estreptococos causan una diversidad de enfermedades, como anginas, shock tóxico estreptocócico y septicemia. Su investigación permite la identificación rápida de estreptococos patógenos específicos por medio de técnica inmunológicas.
Un adelanto fundamental en la inmunología sucedió con Lancefield cuando propuso la clasificación de los estreptococos según serotipos (variantes dentro de una especie) sobre la base de ciertos componentes de la pared celular de las bacterias. Estos estreptococos causan una diversidad de enfermedades, como anginas, shock tóxico estreptocócico y septicemia. Su investigación permite la identificación rápida de estreptococos patógenos específicos por medio de técnica inmunológicas. -
 Stanley demostró que el microorganismo, denominado virus del mosaico del tabaco presentaba características muy diferentes de las de otros microorganismos y eran tan simples y homogéneos que podía ser cristalizado como si fuera un compuesto químico. Este trabajo facilitó el estudio de la estructura y la composición química de los virus
Stanley demostró que el microorganismo, denominado virus del mosaico del tabaco presentaba características muy diferentes de las de otros microorganismos y eran tan simples y homogéneos que podía ser cristalizado como si fuera un compuesto químico. Este trabajo facilitó el estudio de la estructura y la composición química de los virus -
 La primera mitad del siglo XX se desarrollaron de forma extraordinaria las dos disciplinas que son la base de la biología molecular: la genética y la bioquímica. Una de las principales aportaciones fue por Beadle y Tatum. Demostraron que había una correlación entre los genes y las enzimas a través del estudio de las rutas metabólicas implicadas en la síntesis de aminoácidos. Por lo tanto, los procesos celulares podían estudiarse como reacciones químicas.
La primera mitad del siglo XX se desarrollaron de forma extraordinaria las dos disciplinas que son la base de la biología molecular: la genética y la bioquímica. Una de las principales aportaciones fue por Beadle y Tatum. Demostraron que había una correlación entre los genes y las enzimas a través del estudio de las rutas metabólicas implicadas en la síntesis de aminoácidos. Por lo tanto, los procesos celulares podían estudiarse como reacciones químicas. -
 En ese año y con la colaboración de Coli MacLeod y Maclyn McCarty, Avery demostró que aquel principio transformante de Griffth era el ADN: la transformación persistía al tratar los extractos bacterianos con enzimas que rompían las proteínas, mientras que desaparecía al degradar el ADN.
En ese año y con la colaboración de Coli MacLeod y Maclyn McCarty, Avery demostró que aquel principio transformante de Griffth era el ADN: la transformación persistía al tratar los extractos bacterianos con enzimas que rompían las proteínas, mientras que desaparecía al degradar el ADN. -
 Descubrieron que el material genético podía transferirse de una bacteria a otra mediante un proceso denominado conjugación.
Descubrieron que el material genético podía transferirse de una bacteria a otra mediante un proceso denominado conjugación. -
 En 1953 se publicó en la revista Nature el articulo "Estructura molecular de los ácidos nucleicos", escrito por Watson y Crick . Inspirados en estudios cristalográficos de Wilkins y Franklin, que (sugería que la molécula de ADN poseía estructura helicoidal) observaron que los distintos ADN examinados presentaban el mismo número de adenina- timinas y citosinas- guaninas. Propusieron asignar una estructura de doble hélice a la molécula de ADN.
En 1953 se publicó en la revista Nature el articulo "Estructura molecular de los ácidos nucleicos", escrito por Watson y Crick . Inspirados en estudios cristalográficos de Wilkins y Franklin, que (sugería que la molécula de ADN poseía estructura helicoidal) observaron que los distintos ADN examinados presentaban el mismo número de adenina- timinas y citosinas- guaninas. Propusieron asignar una estructura de doble hélice a la molécula de ADN. -
 Jcob y Monod descubrieron el ARN mensajero (ácido ribonucleico), una sustancia química implicada en la síntesis proteica. Posteriormente realizaron observaciones importantes sobre la regulación del funcionamiento de los genes en las bacterias. En ese periodo lograron descifrar el código genético y el modo en que la información para la síntesis de proteínas en el ARN mensajero se traduce en la secuencia de aminoácidos para sintetizar las proteínas.
Jcob y Monod descubrieron el ARN mensajero (ácido ribonucleico), una sustancia química implicada en la síntesis proteica. Posteriormente realizaron observaciones importantes sobre la regulación del funcionamiento de los genes en las bacterias. En ese periodo lograron descifrar el código genético y el modo en que la información para la síntesis de proteínas en el ARN mensajero se traduce en la secuencia de aminoácidos para sintetizar las proteínas. -
 Pionera en el campo de la investigación de la oncología viral, demostró que los virus causantes de cáncer pueden propagarse de un animal a otro. Realizó investigaciones sobre los poliomavirus junto con Bermnice Eddy.
Pionera en el campo de la investigación de la oncología viral, demostró que los virus causantes de cáncer pueden propagarse de un animal a otro. Realizó investigaciones sobre los poliomavirus junto con Bermnice Eddy. -
 Bijerick y Winogradsky, fueron los primeros en demostrar que las bacterias contribuyen al reciclado de elementos vitales entre el suelo y la atmósfera. La ecología microbiana nació con las investigaciones de estos científicos. Hoy se ha ramificado e incluye el estudio de las interacciones microbianas con plantas y animales en el ambiente. Entre las preocupaciones de los ecólogos microbianos existe la contaminación del agua, presencias de sustancias tóxicas en el ambiente.
Bijerick y Winogradsky, fueron los primeros en demostrar que las bacterias contribuyen al reciclado de elementos vitales entre el suelo y la atmósfera. La ecología microbiana nació con las investigaciones de estos científicos. Hoy se ha ramificado e incluye el estudio de las interacciones microbianas con plantas y animales en el ambiente. Entre las preocupaciones de los ecólogos microbianos existe la contaminación del agua, presencias de sustancias tóxicas en el ambiente. -
En el que los microorganismos se estudian en toda su complejidad fisiológica, bioquímica, genética, ecológica, etc., y que supone un extraordinario crecimiento de la Microbiología, el surgimiento de disciplinas microbiológicas especializadas (Virología, Inmunología, etc), y la estrecha imbricación de las ciencias microbiológicas en el marco general de las Ciencias Biológicas
-
 Berg demostró que los fragmentos de DNA humano o animal (gen) que codifican proteínas importantes pueden adherirse al DNA bacteriano. El híbrido resultado fue el DNA recombinante. Cuando este DNA se inserta en bacterias, puede utilizarse para elaborar gran cantidad de proteína deseada. La tecnología que se desarrolló a partir de esta técnica de denomino Tecnología del DNA recombinante o Ingeniería genética.
Berg demostró que los fragmentos de DNA humano o animal (gen) que codifican proteínas importantes pueden adherirse al DNA bacteriano. El híbrido resultado fue el DNA recombinante. Cuando este DNA se inserta en bacterias, puede utilizarse para elaborar gran cantidad de proteína deseada. La tecnología que se desarrolló a partir de esta técnica de denomino Tecnología del DNA recombinante o Ingeniería genética. -
 Sus análisis filogenéticos lo llevaron al descubrimiento de un nuevo dominio, Archaea. Son un grupo de microorganismos prokaryotas unicelulares que, al igual que las bacterias, no presentan núcleo ni orgánulos membranosos, pero son fundamentales a estas que forman su propio domino.
Sus análisis filogenéticos lo llevaron al descubrimiento de un nuevo dominio, Archaea. Son un grupo de microorganismos prokaryotas unicelulares que, al igual que las bacterias, no presentan núcleo ni orgánulos membranosos, pero son fundamentales a estas que forman su propio domino. -
 Blumberg logra obtener una vacuna con un 95% de eficacia contra la hepatitis B.
Blumberg logra obtener una vacuna con un 95% de eficacia contra la hepatitis B. -
 En 1984 se descubre el retrovirus considerado agente etiológico del SIDA. Gallo y Montagnier los Co-Descubridores del VIH.
En 1984 se descubre el retrovirus considerado agente etiológico del SIDA. Gallo y Montagnier los Co-Descubridores del VIH. -
 El genoma de Methanococcus jannaschii fue secuenciado por un grupo en el J. Craig Venter Institute dirigido por Craig Venter utilizando la técnica de secuenciación aleatoria (shotgun sequencing). Según Venter, las características únicas del genoma proporcionan una fuerte evidencia de que hay tres dominios de la vida.
El genoma de Methanococcus jannaschii fue secuenciado por un grupo en el J. Craig Venter Institute dirigido por Craig Venter utilizando la técnica de secuenciación aleatoria (shotgun sequencing). Según Venter, las características únicas del genoma proporcionan una fuerte evidencia de que hay tres dominios de la vida. -
 Descubrió una bacteria lo suficientemente grande como para ser observada a simple vista. Esta bacteria se denominó Thiomargarita namibiensis, vive en el lodo de las costas africanas.
Descubrió una bacteria lo suficientemente grande como para ser observada a simple vista. Esta bacteria se denominó Thiomargarita namibiensis, vive en el lodo de las costas africanas. -
 Theodor von Escherich fue bacteriólogo. Su fama vino dada por ser el descubridor, en 1885, de una bacteria a la que denominó Bacterium coli. Más tarde, los microbiólogos la cambiaron el nombre y pasaron a llamarla Escherichia coli en su honor.
Theodor von Escherich fue bacteriólogo. Su fama vino dada por ser el descubridor, en 1885, de una bacteria a la que denominó Bacterium coli. Más tarde, los microbiólogos la cambiaron el nombre y pasaron a llamarla Escherichia coli en su honor. -
 Hoqwood y col realizaron la secuenciación del genoma Streptomyces coelicolor. Esto sacó a relucir doce grupos de genes (huérfanos) cuya función se desconoce y que aún no se han usado para crear antibióticos. Desde entonces estos genes han sido el objetivo de numerosas investigaciones.
Hoqwood y col realizaron la secuenciación del genoma Streptomyces coelicolor. Esto sacó a relucir doce grupos de genes (huérfanos) cuya función se desconoce y que aún no se han usado para crear antibióticos. Desde entonces estos genes han sido el objetivo de numerosas investigaciones. -
 La gripe por A (H1N1) es una infección respiratoria aguda y muy contagiosa de los cerdos, causada por alguno de los varios virus gripales de tipo A de esa especie. En 2009/10 el mundo vivió una pandemia causada por el virus
La gripe por A (H1N1) es una infección respiratoria aguda y muy contagiosa de los cerdos, causada por alguno de los varios virus gripales de tipo A de esa especie. En 2009/10 el mundo vivió una pandemia causada por el virus -
 Recientemente Capobianchi y Castilletti consiguieron aislar el coronavirus que está causando la pandemia de COVID-19.
Recientemente Capobianchi y Castilletti consiguieron aislar el coronavirus que está causando la pandemia de COVID-19.
Plan projects on a visual timeline
Map milestones, phases, deadlines, and key events in one place so the sequence is easier to see and share. Timetoast is a timeline maker for work, school, research, and stories.